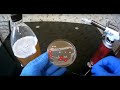

КОРМОВАЯ ДОБАВКА ДЛЯ ПТИЦЕВОДСТВА НЕТ РАСКЛЕВУ
Кормовая добавка для птицеводства "нет расклеву" – это инновационный продукт, разработанный с целью улучшения качества кормов и повышения эффективности производства птицеводства.
Эта добавка разработана специально для предотвращения расклева птиц, что является серьезной проблемой для птицеводов. Расклев птиц ведет к потере питательных веществ, стрессу и снижению производительности.
Кормовая добавка "нет расклеву" содержит уникальные компоненты, которые благотворно влияют на поведение птиц и способствуют уменьшению активности расклева. Она помогает снизить агрессивность птиц, улучшает пищеварение и обеспечивает баланс питательных веществ в организме животных.
Применение этой добавки в кормлении птиц позволяет улучшить их здоровье и благополучие, а также повысить производительность и качество продукции птицеводства.
Выбирая кормовую добавку "нет расклеву", птицеводы могут быть уверены в эффективности и безопасности продукта, который поможет им справиться с расклевом птиц и достичь более высоких результатов в своем бизнесе.
Куры несутся зимой как летом
Расклев и Каннибализм у кур. Решение проблемы за 5 минут когда ничего не помогло
Подкормка для кур: Расклеву Бой! - How to keep chickens from eating their eggs.
Как УВЕЛИЧИТЬ ЯЙЦЕНОСКОСТЬ КУР зимиой ? Соблюдайте эти факторы и ваши куры будут нестись всегда !
Расклев или Каннибализм у кур. Решение проблемы.
Дрожжевание корма// как я его делаю...
Расклев (каннибализм) у цыплят. Ветеринарный врач рекомендует.
ЗООВЕТЕРИНАРНАЯ ТРЕРАПИЯ ОТ РАСКЛЕВА ЯИЦ И КАНИБАЛИЗМА У КУР.
Как СОДА влияет на кур несушек. Как правильно применять соду.